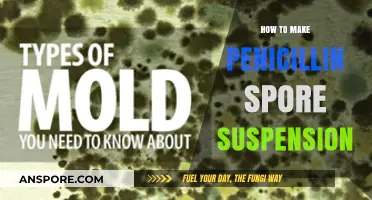
DIY Penicillin Spore Suspension: A Step-by-Step Guide to Homemade Antibiotics

Creating a single spore on one side of an object requires precision and attention to detail. This process involves carefully manipulating the environment and materials to encourage spore growth in a specific, controlled area. Whether for scientific research, artistic purposes, or practical applications, understanding the steps to achieve this can be both fascinating and rewarding. By selecting the right substrate, maintaining optimal conditions such as humidity and temperature, and using techniques like isolation or directed placement, one can successfully cultivate a single spore on the desired side. This method not only showcases the intricacies of spore development but also highlights the importance of patience and accuracy in achieving such a precise outcome.
What You'll Learn
- Prepare the Spore Surface: Clean and sterilize the surface where you'll place the object for sporulation
- Choose the Right Material: Select a spore-friendly material that can withstand the sporulation process
- Apply Spore Suspension: Evenly coat one side of the object with a concentrated spore suspension
- Control Humidity and Temperature: Maintain optimal conditions (high humidity, warm temperature) for spore germination
- Monitor and Incubate: Regularly check the object for spore growth and incubate until fully sporulated

Prepare the Spore Surface: Clean and sterilize the surface where you'll place the object for sporulation
A clean and sterile surface is the foundation for successful sporulation. Any contamination can compromise the process, leading to unwanted bacterial growth or uneven spore distribution. Think of it as preparing a canvas for a masterpiece – the surface must be pristine to ensure the desired outcome.
Before placing your object, meticulously clean the surface with a 70% isopropyl alcohol solution. This concentration effectively kills most bacteria and fungi without leaving harmful residues. Wipe the area thoroughly, ensuring complete coverage, and allow it to air dry completely. Avoid using cloths or materials that may shed fibers, opting for sterile wipes or disposable paper towels instead.
The sterilization process goes beyond simple cleaning. Autoclaving, a method using high-pressure steam, is the gold standard for achieving a sterile environment. If an autoclave is unavailable, dry heat sterilization in an oven at 160°C (320°F) for 2 hours can be effective, though less reliable. Remember, the goal is to eliminate all microorganisms, creating a blank slate for your sporulation experiment.
For delicate surfaces that cannot withstand high temperatures, consider using a chemical sterilant like ethanol or hydrogen peroxide vapor. However, ensure complete removal of any residues before proceeding, as these chemicals can inhibit spore formation.
Imagine the consequences of neglecting surface preparation: a contaminated surface could lead to a failed experiment, wasted resources, and potentially misleading results. By investing time in thorough cleaning and sterilization, you ensure the integrity of your sporulation process, paving the way for accurate observations and reliable conclusions. This meticulous approach is not just a recommendation; it's a necessity for any successful scientific endeavor.
Understanding Mold Spore Size: How Many Microns Are They?
You may want to see also

Choose the Right Material: Select a spore-friendly material that can withstand the sporulation process
The success of your spore project hinges on material compatibility. Sporulation is a demanding process, requiring a substrate that can withstand extreme conditions: desiccation, temperature fluctuations, and chemical exposure. Glass, certain ceramics, and specific polymers like polypropylene excel in this environment. Avoid materials prone to warping, cracking, or chemical degradation, such as untreated plastics or soft metals.
Consider the spore species and its unique requirements. Some fungi, like *Aspergillus niger*, thrive on nutrient-rich agar, while others, such as *Bacillus subtilis*, prefer minimal, inert surfaces. Research the optimal pH, moisture retention, and nutrient availability for your chosen organism. For instance, calcium carbonate-buffered substrates can stabilize pH for acid-sensitive species, while hydrophobic materials like PTFE may hinder spore attachment in moisture-dependent strains.
Practicality matters. While glass slides offer unparalleled durability and chemical resistance, they’re fragile and unsuitable for large-scale production. Polypropylene sheets, on the other hand, are lightweight, affordable, and compatible with most sterilization methods (autoclaving, ethanol wipes). For artistic or decorative spores, consider translucent materials like acrylic or resin, ensuring they’re UV-stable to prevent discoloration under prolonged light exposure.
A critical step often overlooked is surface preparation. Even spore-friendly materials require treatment to enhance adhesion. Sandblasting or chemical etching can create micro-roughness, promoting spore attachment. Alternatively, a thin layer of adhesive (e.g., 0.1% gelatin solution) can be applied, though ensure it doesn’t interfere with sporulation. Always test material compatibility with a small batch before scaling up—some interactions only become apparent under sporulation stress.
In conclusion, choosing the right material is a balance of scientific rigor and practical considerations. Prioritize durability, compatibility, and ease of use, tailoring your selection to the specific demands of your spore species and project goals. With the right substrate, you’ll create an environment where sporulation thrives, not just survives.
Streptococcus Bovis Sporulation: Fact or Fiction? Unraveling the Mystery
You may want to see also

Apply Spore Suspension: Evenly coat one side of the object with a concentrated spore suspension
A critical step in achieving successful sporulation on a single side of an object is the precise application of a concentrated spore suspension. This technique demands attention to detail, as uneven coating can lead to inconsistent results. The goal is to create a uniform layer of spores, ensuring optimal conditions for growth while maintaining the desired one-sided effect.
Technique and Tools: To achieve this, start by preparing a highly concentrated spore suspension, typically ranging from 10^6 to 10^8 spores per milliliter, depending on the species and desired density. Use a sterile technique to avoid contamination. A common method involves dipping or spraying, but for one-sided application, a more controlled approach is necessary. Consider using a small brush, cotton swab, or even a spray bottle with a narrow nozzle to apply the suspension. The key is to maintain a consistent distance and pressure to ensure an even coat.
Application Process: Begin by securing the object in a position that allows easy access to one side while keeping the other side protected or elevated. Gently apply the spore suspension, starting from one edge and moving systematically across the surface. Ensure complete coverage without oversaturating, as excess liquid may lead to runoff and uneven distribution. For larger objects, work in sections, allowing each area to dry slightly before moving to the next, preventing pooling and ensuring a uniform layer.
Cautions and Considerations: Precision is crucial; avoid over-application, as it may result in spore migration to the unintended side. The concentration of the suspension is vital; too dilute, and the coating may be inadequate, while too concentrated can lead to clumping and uneven distribution. Practice and experimentation are key to mastering this technique, as different spore species and object surfaces may require adjustments in application methods and suspension concentrations.
Practical Tips: For delicate objects, consider using a fine mist sprayer to gently apply the suspension. In cases where the object's material is absorbent, pre-treat the surface with a suitable sealant to ensure the spores adhere only to the desired side. Always work in a sterile environment to prevent contamination, and allow sufficient drying time before further handling or incubation. This method is particularly useful in research settings, art installations, or specialized cultivation techniques where controlled sporulation is essential.
Exploring Fungi Reproduction: Sexual, Asexual, or Both?
You may want to see also

Control Humidity and Temperature: Maintain optimal conditions (high humidity, warm temperature) for spore germination
Spore germination is a delicate process that hinges on precise environmental conditions. Among the most critical factors are humidity and temperature, which must be meticulously controlled to encourage successful growth. High humidity levels, typically around 90-100%, create a moist environment essential for spores to absorb water and initiate metabolic activity. Simultaneously, warm temperatures, ideally between 24-28°C (75-82°F), provide the energy needed to drive enzymatic reactions and cellular division. Without these optimal conditions, spores may remain dormant or fail to germinate altogether.
To achieve and maintain these conditions, consider using a humidity dome or a sealed container with a hygrometer to monitor moisture levels. For temperature control, a seedling heat mat or a thermostat-regulated incubator can ensure consistency. If natural humidity is insufficient, misting the environment lightly or placing a tray of water near the spores can help. However, avoid over-saturation, as excessive moisture can lead to mold or fungal contamination. Regularly check and adjust both humidity and temperature to account for fluctuations, especially in fluctuating ambient conditions.
A comparative analysis reveals that while some spore species may tolerate slightly lower humidity or cooler temperatures, deviating from the optimal range significantly reduces germination rates. For instance, * Psilocybe cubensis* spores thrive at 26°C and 95% humidity, while * Aspergillus* species may require slightly cooler conditions. Understanding the specific needs of your target spore species is crucial for tailoring your approach. Online databases and mycological guides can provide species-specific recommendations to refine your setup.
Practical tips include using a spray bottle with distilled water to maintain humidity without introducing contaminants. For temperature regulation, place your setup away from drafts or direct sunlight, which can cause unpredictable fluctuations. If using a heat mat, ensure it’s paired with a thermostat to prevent overheating. For long-term projects, consider investing in a dedicated incubation chamber with built-in humidity and temperature controls. These tools, while initially costly, offer precision and reliability that manual adjustments often lack.
In conclusion, controlling humidity and temperature is not just a step but the cornerstone of successful spore germination. By maintaining high humidity and warm temperatures, you create an environment where spores can thrive. Attention to detail, coupled with the right tools and knowledge, transforms this scientific process into an achievable practice. Whether for research, cultivation, or curiosity, mastering these conditions unlocks the potential of spores to grow and flourish.
Fungal Spores: Unseen, Ubiquitous, and Everywhere Around Us
You may want to see also

Monitor and Incubate: Regularly check the object for spore growth and incubate until fully sporulated
Sporulation is a delicate process, and ensuring that only one side of an object develops spores requires meticulous monitoring and incubation. This technique is often employed in mycology and microbiology to study spore formation or create unique biological art. The key to success lies in creating an environment that encourages spore growth on the desired side while inhibiting it elsewhere.
Observation and Timing: Regularly inspecting the object is crucial. Spore development typically occurs in distinct stages, starting with the formation of a spore-bearing structure, such as a sporangium or ascus. Check for these structures using a magnifying glass or microscope, depending on their size. For example, in fungi, you might observe the development of spore-producing bodies like mushrooms or molds. The incubation period can vary widely, from a few days to several weeks, depending on the organism and environmental conditions. A daily inspection routine is ideal, allowing you to catch any unwanted spore growth on the undesired side early on.
Incubation Techniques: Incubation involves maintaining optimal conditions for spore development. This includes controlling temperature, humidity, and light exposure. For instance, many fungi prefer warm, humid environments, so an incubator set at 25-30°C with high humidity levels can accelerate spore growth. However, be cautious not to create conditions that promote growth on the unwanted side. One method to achieve one-sided sporulation is to expose only the desired side to these optimal conditions, perhaps by using a specialized container or covering the other side with a growth-inhibiting material.
Practical Tips for Success: To ensure a successful one-sided sporulation, consider the following: First, start with a sterile object to prevent contamination from unwanted spores. Second, maintain a consistent incubation environment; sudden changes in temperature or humidity can stress the organism and affect spore development. Third, document your observations daily, noting any changes in color, texture, or structure, as this data will help you understand the sporulation process and refine your technique. Finally, be patient; rushing the process might lead to incomplete sporulation or unwanted growth.
The art of monitoring and incubating for one-sided spore growth is a blend of science and precision. It requires a keen eye for detail and an understanding of the organism's biology. By carefully controlling the environment and regularly observing the object, you can guide the sporulation process to achieve the desired outcome. This technique is not only valuable for scientific research but also opens up creative possibilities in bio-art and design, where controlled spore growth can lead to unique and captivating visual effects.
Mastering Spore: Unlock Infinite Complexity in Your Creations
You may want to see also
Frequently asked questions
This phrase seems to be a cryptic or unconventional term, possibly referring to creating or isolating a single element or organism (like a spore) on one specific side of a medium or environment.
To achieve this, you can use a technique called "streaking." Sterilize a loop, touch it to your spore suspension, and then streak it across one side of the petri dish in a zigzag pattern. Incubate the dish, and a single spore should grow into a colony on that side.
Yes, using a micromanipulator attached to a microscope allows for precise placement of individual spores. This method is often used in research settings for studying spore behavior and genetics.
Common challenges include contamination from other microorganisms, uneven distribution of nutrients, and difficulty in handling individual spores without damaging them. Proper sterilization techniques and practice are essential for success.